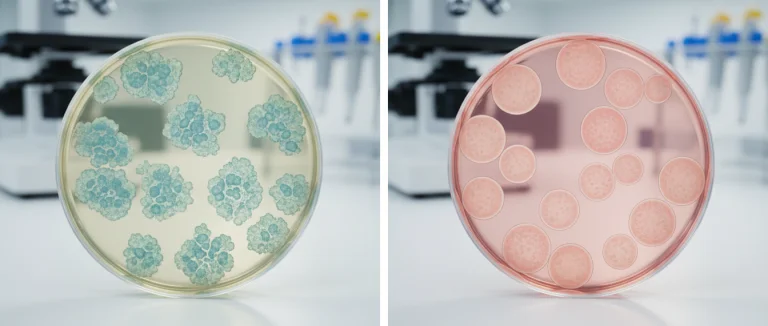
Сравнение iPS и эмбриональных стволовых клеток

Индуцированные iPS клетки: прорыв в регенеративной медицине
-
Что такое индуцированные iPS клетки и как они создаются?
-
Применение iPS клеток в регенеративной медицине
-
Преимущества iPS клеток перед эмбриональными стволовыми клетками
-
Процедуры и протоколы в Лив Хоспитал: от сбора образцов до терапии
-
Будущее iPS технологий: исследования и клинические испытания
-
Почему выбирают Лив Хоспитал
В последние годы индуцированные iPS клетки стали одним из самых обсуждаемых достижений биомедицины, открывая новые возможности для лечения тяжёлых заболеваний. Эти клетки позволяют создавать персонализированные препараты, минимизируя риск отторжения и этические споры, связанные с эмбриональными стволовыми клетками. По данным международных исследований, более 5 000 клинических испытаний уже используют iPS‑технологию, и каждый год количество новых проектов растёт более чем на 30 %.
Статья раскрывает, как именно получают такие клетки, какие области медицины уже выигрывают от их применения и почему Лив Хоспитал предлагает передовые протоколы терапии стволовыми клетками для иностранных пациентов. Мы также обсудим перспективы развития iPS‑терапии и её влияние на будущее регенеративной медицины.
Если вы ищете надёжного партнёра для получения инновационного лечения, ознакомьтесь с нашими рекомендациями и узнайте, как индуцированные iPS клетки могут стать ключом к восстановлению здоровья.
Что такое индуцированные iPS клетки и как они создаются?
Термин индуцированные iPS клетки (iPSC) обозначает соматические клетки, пере‑программированные в состояние плюрипотентности с помощью специфических генетических факторов. Впервые такой метод был описан японским учёным Шинья Яманакой в 2006 году, где он использовал четыре гена‑фактора, ныне известных как факторы Яманаки: OCT4, SOX2, KLF4 и c-MYC.
- Получение образца: берут кожу или кровь пациента.
- Введение факторов: используют вирусные векторы или безопасные нон‑вирусные методы (мРНК, плазмиды).
- Репрограммирование: клетки начинают экспрессировать гены, характерные для плюрипотентных стволовых клеток.
- Отбор и культивирование: выделяют колонии, способные дифференцироваться в любые типы тканей.
В результате получаются индуцированные плюрипотентные стволовые клетки, которые могут превращаться в нейроны, кардиомиоциты, клетки печени и другие типы, необходимые для восстановления повреждённых органов.
| Этап | Метод | Ключевые особенности |
|---|---|---|
| Сбор образца | Биопсия кожи / забор крови | Минимально инвазивно, безопасно |
| Введение факторов | Вирусные векторы, мРНК, плазмиды | Выбор зависит от требуемой эффективности и безопасности |
| Репрограммирование | Экспрессия OCT4, SOX2, KLF4, c-MYC | Плюрипотентность подтверждается маркерами |
| Культивирование | Специальные среды, 3D‑структуры | Получение стабильных колоний |

Применение iPS клеток в регенеративной медицине
Сегодня iPSC находят применение в самых разнообразных областях: от лечения нейродегенеративных болезней до восстановления сердечной ткани после инфаркта. Ниже перечислены ключевые направления, где уже наблюдаются клинические успехи.
- Нейрология: дифференцированные нейроны из iPS клеток используются в терапии Паркинсона, Альцгеймера и спинальной мышечной атрофии.
- Кардиология: кардиомиоциты, полученные из iPS, позволяют восстанавливать повреждённую миокарду и проводить тестирование новых препаратов.
- Гепатология: гепатоциты iPS помогают в лечении цирроза и острой печёночной недостаточности.
- Ортопедия: хрящевые и костные ткани, полученные из iPS, применяются при регенерации суставов и лечения остеоартрита.
- Эндокринология: создание β‑клеток поджелудочной железы открывает перспективы лечения диабета 1 типа.
Ключевым преимуществом является возможность создания автологичных (пациент‑специфичных) тканей, что значительно снижает риск иммунного отторжения. Кроме того, iPS клетки позволяют проводить скрининг новых лекарств на человеческом генетическом фоне, ускоряя процесс разработки препаратов.

Преимущества iPS клеток перед эмбриональными стволовыми клетками
Эмбриональные стволовые клетки (ЭСК) долгое время считались золотым стандартом из‑за их высокой плюрипотентности. Однако индуцированные iPS клетки обладают рядом преимуществ, делающих их более предпочтительными для клинического применения.
- Этическая безопасность: iPS клетки получают из взрослых тканей, без необходимости использования эмбрионов.
- Индивидуализация: клетки берутся у самого пациента, что исключает необходимость иммуносупрессивной терапии.
- Генетическая совместимость: снижается риск генетических аномалий, характерных для некоторых линий ЭСК.
- Гибкость производства: процесс создания iPS клеток может быть масштабирован в лабораторных условиях без ограничения количества образцов.
Исследования показывают, что при правильных протоколах риск опухолевой трансформации у iPS клеток сопоставим с риском у ЭСК, а в некоторых случаях даже ниже благодаря использованию безвирусных методов репрограммирования.
Важным аспектом является также возможность создания моделей заболеваний «на лету», когда iPS клетки пациента дифференцируются в клетки поражённого органа, позволяя изучать патогенез и тестировать препараты в индивидуальном контексте.
Процедуры и протоколы в Лив Хоспитал: от сбора образцов до терапии
Лив Хоспитал предлагает полностью интегрированный путь лечения с использованием индуцированных iPS клеток, адаптированный под нужды иностранных пациентов. Процесс включает несколько этапов, каждый из которых контролируется международными стандартами качества JCI.
1. Консультация и планирование
После первичного онлайн‑запроса пациент получает персонального координатора, который организует видеоконсультацию с ведущим специалистом по стволовым клеткам. На этом этапе обсуждаются цели лечения, возможные риски и ожидаемые результаты.
2. Сбор биоматериала
В клинике Лив Хоспитал берут небольшую биопсию кожи или кровь. Для иностранных пациентов предусмотрен трансфер образцов в специализированный центр лаборатории, где соблюдаются условия холодовой цепи и стерильности.
3. Репрограммирование и контроль качества
Лаборатория использует безвирусные мРНК‑векторы для введения факторов Яманаки, минимизируя генетический риск. Каждый полученный клон проходит проверку на плюрипотентность (маркерные гены OCT4, NANOG) и отсутствие кариотипных аномалий.
4. Дифференцировка и подготовка к трансплантации
В зависимости от клинической задачи клетки дифференцируют в нужный тип ткани (нейроны, кардиомиоциты, хрящевые клетки). Затем проводится тестирование их функциональности в vitro, а также оценка потенциальной иммуностимуляции.
5. Трансплантация и постоперационный мониторинг
Терапия проводится в специально оборудованном операционном зале с поддержкой роботизированных систем. После процедуры пациент находится под наблюдением в реабилитационном центре, где ежедневно измеряют биомаркеры, проводят МРТ и другие исследования для контроля за интеграцией трансплантированных клеток.
Весь процесс сопровождается переводчиком, транспортом от аэропорта до отеля и поддержкой в выборе комфортного размещения, что делает лечение в Лив Хоспитал удобным для пациентов из любой страны.
Будущее iPS технологий: исследования и клинические испытания
Научное сообщество прогнозирует, что к 2030 году более 30 % всех регенеративных терапий будет основано на индуцированных iPS клетках. Основные направления будущих исследований включают:
- Геномная стабилизация: разработка методов редактирования CRISPR для коррекции наследственных мутаций в iPS перед их дифференцировкой.
- Биоинженерия тканей: создание 3‑мерных органоидов и биопринтинг, позволяющих формировать сложные структуры, такие как мини‑печень или мини‑сердце.
- Персонализированная онкология: использование iPS‑клеток пациента для скрининга химиотерапевтических препаратов с учётом индивидуального генетического профиля.
- Иммунотерапия: генерация iPS‑дериватов, способных модулировать иммунный ответ при аутоиммунных заболеваниях.
Лив Хоспитал уже участвует в международных консорциумах, где тестируются новые протоколы применения iPS клеток в лечении редких генетических болезней. Пациенты могут стать частью этих клинических исследований, получая доступ к передовым методикам до их широкого внедрения.
Таким образом, индуцированные iPS клетки открывают путь к персонализированной, безопасной и эффективной медицине будущего, а Лив Хоспитал готов стать надёжным проводником в эту новую эру лечения.
Почему выбирают Лив Хоспитал
Лив Хоспитал — частная группа аккредитованных JCI больниц в Стамбуле, специализирующаяся на международных пациентах. Мы предлагаем полный спектр услуг: от записи на приём и организации трансфера до персонального переводчика и помощи с размещением. Наши программы терапии стволовыми клетками основаны на последних мировых исследованиях, а команда врачей имеет многолетний опыт работы с iPS технологиями. Выбирая нас, вы получаете доступ к передовым протоколам, гарантированный контроль качества и поддержку на каждом этапе лечения.
Готовы сделать первый шаг к восстановлению здоровья с помощью индуцированных iPS клеток? Свяжитесь с нашим международным координатором уже сегодня и узнайте, как Лив Хоспитал может помочь вам реализовать индивидуальный план терапии.
Часто задаваемые вопросы
Индуцированные плюрипотентные стволовые клетки (iPS) получаются из взрослых клеток пациента, например кожи или крови. В лаборатории в клетки вводятся четыре ключевых гена‑фактора (OCT4, SOX2, KLF4, c‑MYC) с помощью вирусных векторов или безопасных нон‑вирусных методов, таких как мРНК. После введения факторов клетки «перепрограммируются», приобретая способность дифференцироваться в любые типы тканей. Полученные колонии отбираются, проверяются на плюрипотентность маркерами (OCT4, NANOG) и кариотипную стабильность, после чего их можно направлять к дифференцировке в нужные клетки, например нейроны или кардиомиоциты.
Эмбриональные стволовые клетки требуют использования эмбрионов, что вызывает этические споры. iPS клетки получают из тканей самого пациента, поэтому они полностью автологичны, что исключает необходимость иммуносупрессивной терапии и минимизирует риск иммунного отторжения. Кроме того, процесс их получения масштабируем и не ограничен количеством доступных эмбрионов. При правильных протоколах риск опухолевой трансформации у iPS клеток сопоставим или ниже, чем у ЭСК, особенно при использовании безвирусных методов репрограммирования. Это делает iPS клетки более предпочтительными для клинического применения.
Клинические проекты уже демонстрируют успехи iPS‑клеток в лечении болезней Паркинсона, Альцгеймера и спинальной мышечной атрофии, где дифференцированные нейроны заменяют повреждённые. В кардиологии кардиомиоциты из iPS помогают восстанавливать миокард после инфаркта и тестировать новые препараты. Гепатоциты iPS применяются при циррозе печени и острой печёночной недостаточности. В ортопедии создаются хрящевые и костные ткани для регенерации суставов. В эндокринологии из iPS получают β‑клетки поджелудочной железы для терапии диабета 1 типа.
* Содержимое нашего сайта предназначено только для информационных целей. Обязательно обратитесь к врачу для диагностики и лечения. В содержание страницы не включены элементы, содержащие информацию о терапевтических медицинских услугах в Лив Госпитале.